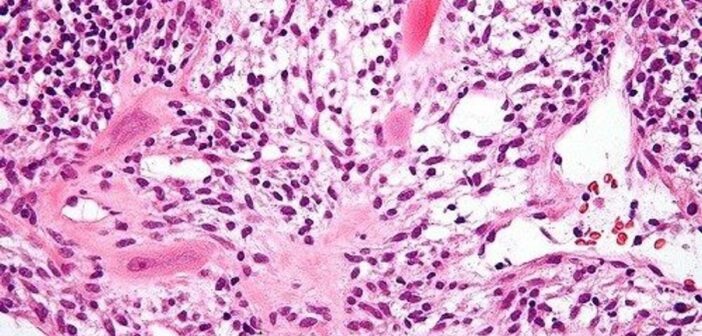

A Hofbauer-sejtek az emberi méhlepény magzati eredetű immunsejtpopulációja. A speciális sejtek génexpresszióját és génexpresszió-szabályozását leíró publikáció a Debreceni Egyetem Klinikai Központ Szülészeti és Nőgyógyászati Klinika, illetve az Általános Orvostudományi Kar Biokémiai és Molekuláris Biológiai Intézet (BMBI) Magreceptor kutatócsoport többéves együttműködésének eredményeként jelent meg.
– A Hofbauer-sejtek elsőként még a 2000-es évek elején kerültek a Magreceptor kutatócsoport munkájának fókuszába. Az a kezdeményezés sajnos korlátokba ütközött, hiszen nem tudtunk nagy tisztaságban Hofbauer-sejteket izolálni. Ezt követően mintegy két évtizeden át úgymond „jegeltük” a témát, de mintegy húsz évvel később ismét felmerült, hogy ezzel a különleges emberi sejttípussal kísérletezzünk. Ekkor elhatároztuk, hogy újra nekifutunk a Hofbauer-projektnek és megpróbáljuk megfejteni, hogy különleges funkcióikat milyen genetikai és genomikai folyamatok szabályozzák. Első lépésként a Yale Egyetem kutatói, Seth Guller, valamint Zhonghua Tang – akikkel azóta is nagyon jó szakmai kapcsolatot ápolunk és a cikknek is társszerzői – rendelkezésünkre bocsátották az általuk kidolgozott sejtizolációs protokollt, így nekünk azt már csak optimalizálni kellett – mondta el a hirek.unideb.hu-nak Nagy László, a DE ÁOK Biokémiai és Molekuláris Biológiai Intézet egyetemi tanára.
A projekt végül 2023 tavaszán előzetes tervezéssel, az etikai engedélyek megszerzésével, az izoláláshoz szükséges reagensek megrendelésével kezdődött el azzal a céllal, hogy elsőként adjanak részletes leírást az egészséges emberi Hofbauer-sejtek génexpressziós és úgynevezett epigenetikai profiljáról és fehérje szintű heterogenitásáról.
A kutatáshoz csatlakozott Baráth Benjámin PhD-hallgató, aki azóta is összefogja a vizsgálat elméleti és gyakorlati részét. A tudományos munkához elengedhetetlen volt egy olyan klinikus bevonása is, aki segíti a kutatás klinikai aspektusának kidolgozását és koordinálását. Deli Tamás, a Szülészeti és Nőgyógyászati Klinika részlegvezetője a kezdetektől proaktív és fontos résztvevője volt a tudományos munkának, melyet professzionális hozzáállásával a klinika minden dolgozója támogatott.
A kutatást az Immunológiai Intézet (Tóth Márta) és a Szegedi Biológiai Kutatóközpont (Szebeni Gábor és Neuperger Patrícia) szakemberei is segítették. A kapott adatok bioinformatikai analízisét és értelmezését Bojcsuk Dóra tudományos munkatárs vezetésével végezték el.
Az eddigi eredményeket tavaly év végén a klinikai fókuszú felfedező kutatások egyik magas besorolású, amerikai székhelyű folyóiratában, a JCI Insight-ban tették közzé. A projekt a Debreceni Egyetem tudományos műhelyei és betegellátó egységei közötti hatékony együttműködés kiemelkedő, nemzetközi szinten is számottevő eredményeket felmutató példája.
– A cikkben a Hofbauer-sejtek génexpresszióját és kromatinnyitottsági profilját más szöveti rezidens makrofágokkal (egy speciális immunsejt populáció) hasonlítottuk össze. Ezek alapján Hofbauer-sejtekben karakterisztikusan magasan és alacsonyan kifejeződő géneket találtunk, mely profil alapján funkcionális jellegzetességek is kirajzolódtak a sejttípusról. Az eredményeink alapján a Hofbauer-sejtek fontos szerepet játszanak a méhlepény érképződésében, keringésének a szabályozásában, a sejtek közötti állományának felépítésében, és ami talán a legizgalmasabb számunkra, a méhlepény zsíranyagcseréjében is. Ez utóbbit alátámasztja az is, hogy az eredményeink alapján számos magreceptor kiemelkedő génexpressziót szabályozó jelentőséggel bír a Hofabuer-sejtekben – ismertette Baráth Benjámin, a cikk egyik elsőszerzője.
A projektben eddig huszonöt méhlepény vizsgálatát végezték el. A kutatásba elsősorban tervezett (elektív) császármetszésen átesett, szülészeti szempontból komplikációmentes kismamákat vontak be. A kutatók hangsúlyozzák: ezek a vizsgálatok értékes alapként szolgálhatnak a későbbi projektekhez, amikor a sejttípus várandóssági komplikációkban betöltött szerepét vizsgálhatják, melyek a jövőben akár új terápiás megközelítések feltérképezésében is kiindulási alapként szolgálhatnak.
– A Szülészeti és Nőgyógyászati Klinika regionális centrumként nemcsak a szükséges méhlepény-mintákat és a betegpopulációt tudja biztosítani, hanem a terhességek teljes klinikai hátterét is ismerjük, mivel a patológiás esetek ellátása is nálunk történik. Ez különösen értékes, hiszen a normál terhességek mellett számos, a méhlepényt érintő kórállapot – például terhességi toxémia (preeklampszia) vagy terhességi cukorbetegség (gesztációs diabétesz) – is bevonható a vizsgálatba. Kiemelt előnyünk a tervezhetőség: a programozott császármetszések révén a mintavétel és a laboratóriumi feldolgozás pontosan időzíthető, így a méhlepény friss állapotban, azonnal vizsgálható. Ez nemzetközi összehasonlításban is jelentős versenyelőny. A stabil betegkör, az elkötelezett klinikusok és a jól szervezett szakdolgozói háttér együttesen biztosítják a magas színvonalú, megbízható kutatási környezetet – emelte ki Krasznai Zoárd egyetemi docens, a Debreceni Egyetem Klinikai Központ Szülészeti és Nőgyógyászati Klinika igazgatója és Deli Tamás, a klinika perinatológiai részlegvezetője.
A most megjelent cikk a projekt első fázisának az eredménye, jelenleg egy másik sejttípussal, a trophoblasztokkal is kísérleteznek Debrecenben, emellett több mint egy éve egy amerikai kollaboráció keretében a Hofbauer-sejtek és trophoblasztok interakcióját vizsgáló kísérletsorozat is folyamatban van a Johns Hopkins Egyetem St. Petersburgben található floridai campusán.
Forrás: Debreceni Egyetem